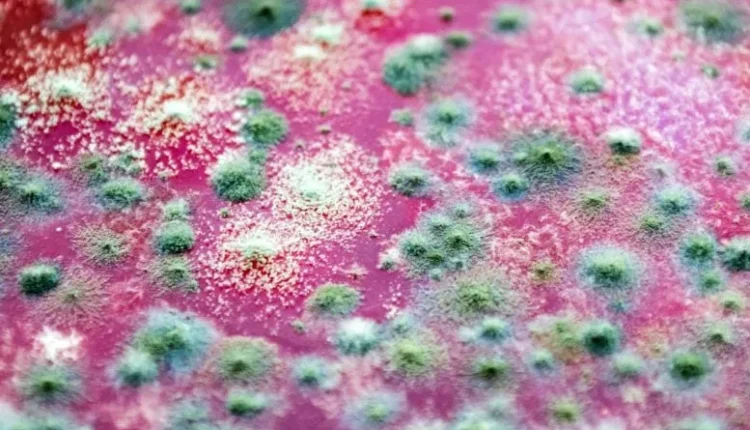

Συναγερμός για τους «Υπερμύκητες»
Τα Φυτοφάρμακα Εκτρέφουν την Επόμενη Πανδημία; Ειδικοί Προειδοποιούν για Θανατηφόρους «Υπερμύκητες»
Καθώς ο κόσμος ακόμα προσπαθεί να συνέλθει από την πανδημία του COVID-19, οι επιστήμονες κρούουν τον κώδωνα του κινδύνου για μια νέα, ύπουλη απειλή που δεν προέρχεται από ιούς, αλλά από μύκητες. Συγκεκριμένα, μια αυξανόμενη ανησυχία επικεντρώνεται στον τρόπο με τον οποίο η ευρεία χρήση φυτοφαρμάκων στη γεωργία μπορεί να δημιουργεί ανθεκτικούς «υπερμύκητες» (fungal superbugs), ικανούς να προκαλέσουν θανατηφόρες λοιμώξεις στον άνθρωπο, οι οποίες δεν ανταποκρίνονται στις υπάρχουσες θεραπείες.
Η Κρυφή Σύνδεση: Γεωργία και Ανθρώπινη Υγεία
Στο επίκεντρο του προβλήματος βρίσκεται η χρήση των μυκητοκτόνων, μιας κατηγορίας φυτοφαρμάκων που χρησιμοποιούνται μαζικά για την προστασία των καλλιεργειών από τη μούχλα και άλλες μυκητιασικές ασθένειες. Η πιο κοινή κατηγορία αυτών των χημικών είναι οι αζόλες (azoles).
Το πρόβλημα είναι ότι οι αζόλες δεν χρησιμοποιούνται μόνο στη γεωργία. Αποτελούν επίσης την πρώτη γραμμή άμυνας στην ιατρική για τη θεραπεία σοβαρών μυκητιασικών λοιμώξεων στον άνθρωπο. Αυτή η διπλή χρήση δημιουργεί ένα επικίνδυνο σενάριο εξέλιξης και ανθεκτικότητας.
Ο Μηχανισμός της Ανθεκτικότητας: Πώς Δημιουργούνται οι Υπερμύκητες
Ένας από τους πιο διαδεδομένους και επικίνδυνους μύκητες είναι ο Aspergillus fumigatus, μια κοινή μούχλα που βρίσκεται στο περιβάλλον, στο χώμα και σε φυτικά υπολείμματα. Οι σπόροι του αιωρούνται στον αέρα και τους εισπνέουμε καθημερινά. Για τους περισσότερους υγιείς ανθρώπους, αυτό δεν αποτελεί πρόβλημα. Ωστόσο, για άτομα με εξασθενημένο ανοσοποιητικό σύστημα (π.χ. ασθενείς με καρκίνο, μεταμοσχευμένους, ασθενείς σε ΜΕΘ), ο Aspergillus μπορεί να προκαλέσει μια θανατηφόρα λοίμωξη που ονομάζεται ασπεργίλλωση.
Όταν οι αγρότες ψεκάζουν τις καλλιέργειες με αζόλες, σκοτώνουν τους ευαίσθητους μύκητες. Ωστόσο, τα στελέχη του Aspergillus που τυχαίνει να έχουν φυσική αντοχή επιβιώνουν και πολλαπλασιάζονται, κυριαρχώντας στο περιβάλλον. Όταν ένας άνθρωπος εισπνεύσει αυτούς τους ανθεκτικούς σπόρους και αναπτύξει λοίμωξη, τα φάρμακα που θα του χορηγήσουν οι γιατροί (τα οποία είναι επίσης αζόλες) δεν θα λειτουργήσουν.
Μια Αυξανόμενη Παγκόσμια Απειλή
Ειδικοί από κορυφαία ιδρύματα, όπως το Imperial College του Λονδίνου, προειδοποιούν ότι η ανθεκτικότητα των μυκήτων στα φάρμακα αυξάνεται παγκοσμίως με ανησυχητικούς ρυθμούς. Σε αντίθεση με την ανθεκτικότητα των βακτηρίων στα αντιβιοτικά (μικροβιακή αντοχή – AMR), η οποία έχει λάβει μεγάλη δημοσιότητα, η απειλή των ανθεκτικών μυκήτων παραμένει σε μεγάλο βαθμό υποτιμημένη.
Οι μυκητιασικές λοιμώξεις σκοτώνουν ήδη περισσότερους ανθρώπους ετησίως από ό,τι η ελονοσία. Καθώς ο αριθμός των ανοσοκατεσταλμένων ασθενών αυξάνεται (λόγω γήρανσης του πληθυσμού, καλύτερων θεραπειών για τον καρκίνο και πανδημιών όπως ο COVID-19 που βλάπτουν τους πνεύμονες), η ευαλωτότητα σε αυτούς τους υπερμύκητες μεγαλώνει.
Το Σενάριο της Πανδημίας: Πόσο Πιθανό Είναι;
Αν και ένα σενάριο τύπου “The Last of Us” (η δημοφιλής σειρά όπου ένας μύκητας μετατρέπει τους ανθρώπους σε ζόμπι) παραμένει επιστημονική φαντασία, ο κίνδυνος μιας πανδημίας από έναν εξαιρετικά ανθεκτικό και μεταδοτικό μύκητα είναι υπαρκτός. Μύκητες όπως ο Candida auris, ο οποίος είναι ήδη πολυανθεκτικός και εξαπλώνεται ταχύτατα σε νοσοκομειακά περιβάλλοντα παγκοσμίως, αποτελούν μια ζωντανή απόδειξη αυτής της απειλής.
Η Ανάγκη για Δράση: Επιτήρηση και Νέα Φάρμακα
Οι επιστήμονες τονίζουν την επείγουσα ανάγκη για συντονισμένη δράση σε πολλαπλά επίπεδα:
-
Περιορισμός της Χρήσης στη Γεωργία: Απαιτείται αυστηρότερη ρύθμιση και έλεγχος της χρήσης αζολών στη γεωργία για να μειωθεί η πίεση που οδηγεί στην ανάπτυξη ανθεκτικότητας.
-
Παγκόσμια Επιτήρηση: Χρειάζεται καλύτερη παρακολούθηση και χαρτογράφηση των ανθεκτικών στελεχών μυκήτων στο περιβάλλον και σε κλινικά περιστατικά.
-
Ανάπτυξη Νέων Φαρμάκων: Η φαρμακευτική έρευνα για νέα αντιμυκητιασικά φάρμακα είναι δραματικά υποχρηματοδοτούμενη. Υπάρχουν ελάχιστες νέες κατηγορίες φαρμάκων υπό ανάπτυξη, αφήνοντάς μας εξαιρετικά ευάλωτους εάν οι αζόλες καταστούν άχρηστες.
Η διασύνδεση της γεωργικής πρακτικής με τη δημόσια υγεία δεν ήταν ποτέ πιο ξεκάθαρη. Η αποτυχία να δράσουμε τώρα ενάντια στην άνοδο των υπερμυκήτων μπορεί να μας κοστίσει ακριβά στο μέλλον.
[via]
